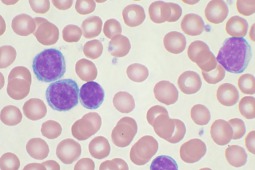

Decyzja CHMP w sprawie stosowania leku Zydelig
Komitet ds. Produktów Leczniczych Stosowanych u Ludzi (Committee for Medicinal Products for Human Use, CHMP) potwierdził, że korzyści płynące ze stosowania leku Zydelig (idelalisib) w leczeniu nowotworów krwi, przewlekłej białaczce limfocytowej (CLL) oraz chłoniaku grudkowym przeważają nad ryzykiem związanym z działami niepożądanymi.
Jednak, po przeprowadzeniu przeglądu danych, zaktualizowano zalecenia mające na celu zminimalizowanie ryzyka poważnych infekcji u pacjentów leczonych tym lekiem.
Wszyscy pacjenci leczeni produktem leczniczym Zydelig powinni przyjmować leki zapobiegające infekcji płuc przez Pneumocystis jirovecii w trakcie leczenia i także do sześciu miesięcy od zakończenia leczenia. Należy również obserwować pacjentów przyjmujących lek Zydelig pod kątem oznak infekcji i poddawać ich regularnym badaniom krwi w celu dokonania pomiaru białych krwinek.
Niski poziom białych krwinek może oznaczać podwyższone ryzyko infekcji i może być konieczne przerwanie leczenia. Terapii lekiem Zydelig nie należy rozpoczynać u pacjentów z uogólnioną infekcją.
Wszyscy pacjenci leczeni produktem leczniczym Zydelig powinni przyjmować leki zapobiegające infekcji płuc przez Pneumocystis jirovecii w trakcie leczenia i także do sześciu miesięcy od zakończenia leczenia. Należy również obserwować pacjentów przyjmujących lek Zydelig pod kątem oznak infekcji i poddawać ich regularnym badaniom krwi w celu dokonania pomiaru białych krwinek.
Niski poziom białych krwinek może oznaczać podwyższone ryzyko infekcji i może być konieczne przerwanie leczenia. Terapii lekiem Zydelig nie należy rozpoczynać u pacjentów z uogólnioną infekcją.



